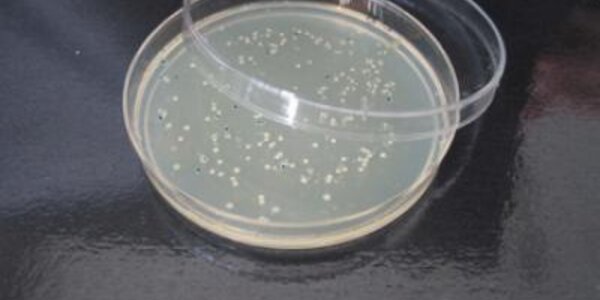
Article teaser image

How Many Lives Does The Chicken Pox Vaccine Save?
The widespread introduction of a chicken pox vaccine in Australia in 2006 has prevented thousands of children from being hospitalized with severe chicken pox and saved lives, according to a national study of chicken pox admissions at four participating Australian children's hospitals.
Chicken pox is a highly contagious infection spread by airborne transmission or from direct contact with the fluid from skin lesions caused by the disease. In its most serious form, chicken pox can cause severe and multiple complications, including neurological conditions, and even death.
Researchers found the…